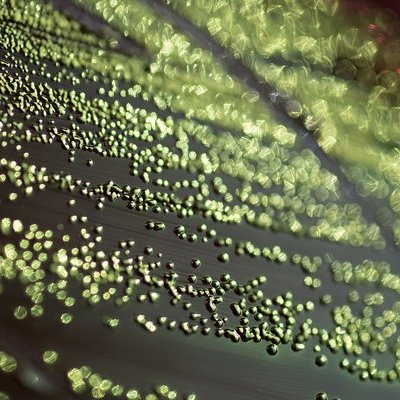

Власти ХМАО-Югры проводят проверку по поводу выявления симптомов пищевой инфекции у 94 пациентов Центра диагностики и сердечно-сосудистой хирургии
Источником кишечной инфекции, обнаруженной у 94 пациентов кардиоцентра в Югре стали продукты питания.
На сегодняшний день 58 пациентов с симптомами острой кишечной инфекции переведены в инфекционное отделение. Треть из них получает лечение амбулаторно, поскольку заболевание проходит бессимптомно. Троим организовано лечение в изолированных помещениях на площадях кардиоцентра. Тяжелых пациентов нет, отметил заместитель губернатора ХМАО Всеволод Кольцов.
Все пациенты обеспечены качественной медицинской помощью и находятся под наблюдением медиков, обеспечены необходимыми медикаментами. В кардиодиспансере проводится тотальная дезинфекция. Эксперты проводят санитарно-эпидемиологическое расследование.
Комиссия уточняет источники и возможных поставщиков некачественной продукции, проводится комплексная проверка работы пищеблока. На время противоэпидемических мероприятий диспансер приостановил плановую госпитализацию. Ожидается, что учреждение вернется к плановой работе в течении 2-3 дней.
После данного инцидента проверки правил соблюдения условий питания пройдут во всех учреждениях здравоохранения, социальной защиты и образования. Роспотребнадзором инициировано проведение межведомственной санитарно-противоэпидемической комиссии при правительстве региона, решением которой комплекс профилактических мер расширен на другие пищеблоки социальных объектов.
Фото: Wikimedia Commons/Own work, Джин Дрендель, ( Creative Commons Attribution 4.0 International.)
Подписывайтесь на NewsInfo.Ru